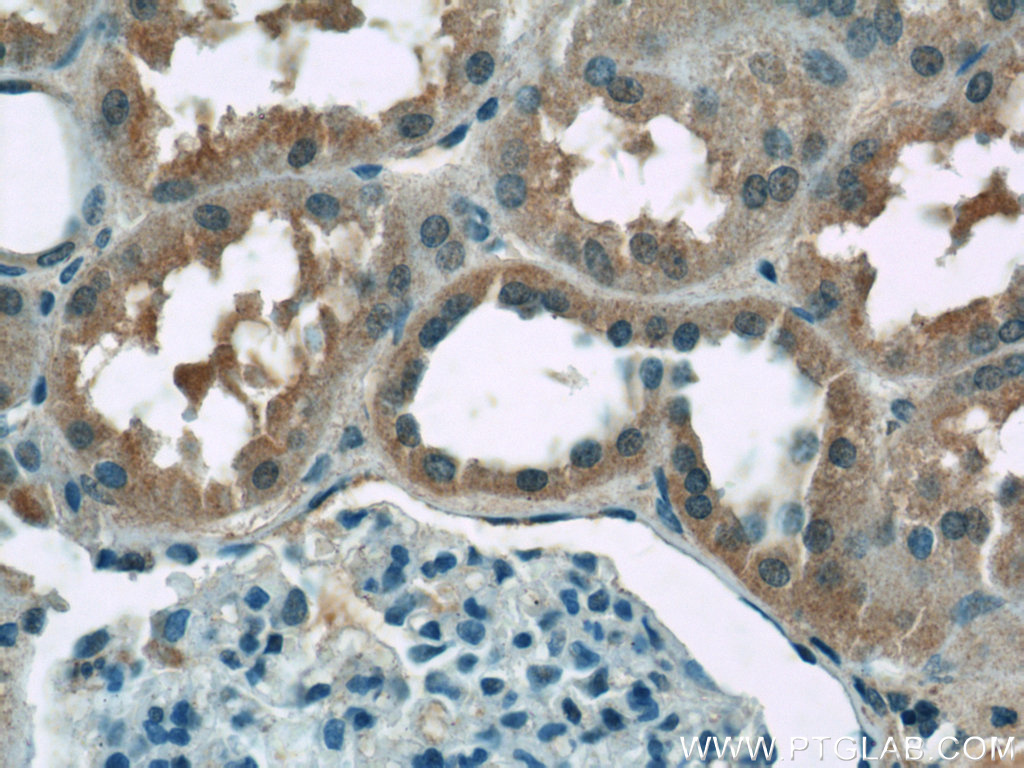

验证数据展示
经过测试的应用
| Positive WB detected in | mouse lung tissue, mouse heart tissue, U-937 cells, mouse liver tissue |
| Positive IP detected in | mouse liver tissue |
| Positive IHC detected in | human kidney tissue, human placenta tissue, mouse lung tissue, mouse small intestine tissue, mouse kidney tissue Note: suggested antigen retrieval with TE buffer pH 9.0; (*) Alternatively, antigen retrieval may be performed with citrate buffer pH 6.0 |
推荐稀释比
| 应用 | 推荐稀释比 |
|---|---|
| Western Blot (WB) | WB : 1:500-1:2400 |
| Immunoprecipitation (IP) | IP : 0.5-4.0 ug for 1.0-3.0 mg of total protein lysate |
| Immunohistochemistry (IHC) | IHC : 1:50-1:500 |
| It is recommended that this reagent should be titrated in each testing system to obtain optimal results. | |
| Sample-dependent, Check data in validation data gallery. | |
产品信息
20459-1-AP targets ZIP8 in WB, IHC, IF, IP, ELISA applications and shows reactivity with human, mouse samples.
| 经测试应用 | WB, IHC, IP, ELISA Application Description |
| 文献引用应用 | WB, IHC, IF |
| 经测试反应性 | human, mouse |
| 文献引用反应性 | human, mouse, rat, pig, bovine |
| 免疫原 |
CatNo: Ag14292 Product name: Recombinant human SLC39A8 protein Source: e coli.-derived, PGEX-4T Tag: GST Domain: 18-143 aa of BC012125 Sequence: LGGVAEGPGLAFSEDVLSVFGANLSLSAAQLQHLLEQMGAASRVGVPEPGQLHFNQCLTAEEIFSLHGFSNATQITSSKFSVICPAVLQQLNFHPCEDRPKHKTRPSHSEVWGYGFLSVTIINLAS 种属同源性预测 |
| 宿主/亚型 | Rabbit / IgG |
| 抗体类别 | Polyclonal |
| 产品类型 | Antibody |
| 全称 | solute carrier family 39 (zinc transporter), member 8 |
| 别名 | BIGM103, SLC39A8, ZIP 8, BCG-induced integral membrane protein in monocyte clone 103 protein, LIV-1 subfamily of ZIP zinc transporter 6 |
| 计算分子量 | 460 aa, 50 kDa |
| 观测分子量 | 42-46 kDa, 75-90 kDa |
| GenBank蛋白编号 | BC012125 |
| 基因名称 | ZIP8 |
| Gene ID (NCBI) | 64116 |
| RRID | AB_10697830 |
| 偶联类型 | Unconjugated |
| 形式 | Liquid |
| 纯化方式 | Antigen affinity purification |
| UNIPROT ID | Q9C0K1 |
| 储存缓冲液 | PBS with 0.02% sodium azide and 50% glycerol, pH 7.3. |
| 储存条件 | Store at -20°C. Stable for one year after shipment. Aliquoting is unnecessary for -20oC storage. |
背景介绍
SLC39A8, also known as ZIP8, belongs to the ZIP family of metal ion transporters which function to transport zinc and/or other metal ion substrates from the extracellular space or organellar lumen into the cytoplasm. Recently it was found that ZIP8 expression is upregulated in human monocytes in response to LPS, TNF-α, and live bacteria, facilitating cytoprotection during the early inflammation. Besides zinc ZIP8 can also transport cadmium and manganese efficiently. It is predicted that ZIP8 contains 3 potential N-linked glycosylation sites and is subject to glycosylation, which may account for the presences of multiple molecular weights, such as 43 kDa, 49 kDa, 60 kDa, 75-90 kDa, 150 kDa, and 200 kDa.
实验方案
| Product Specific Protocols | |
|---|---|
| IHC protocol for ZIP8 antibody 20459-1-AP | Download protocol |
| IP protocol for ZIP8 antibody 20459-1-AP | Download protocol |
| WB protocol for ZIP8 antibody 20459-1-AP | Download protocol |
| Standard Protocols | |
|---|---|
| Click here to view our Standard Protocols |
发表文章
| Species | Application | Title |
|---|---|---|
Nat Commun The manganese transporter SLC39A8 links alkaline ceramidase 1 to inflammatory bowel disease | ||
J Clin Invest Hepatic metal ion transporter ZIP8 regulates manganese homeostasis and manganese-dependent enzyme activity.
| ||
Adv Healthc Mater A 3D Co-Culture System Inspired by Fracture Healing Cell Interactions for Bone Tissue Engineering | ||
Acta Neuropathol Commun Deregulation of subcellular biometal homeostasis through loss of the metal transporter, Zip7, in a childhood neurodegenerative disorder. | ||
Int J Mol Sci Mitochondria-Targeting Antioxidant Provides Cardioprotection through Regulation of Cytosolic and Mitochondrial Zn2+ Levels with Re-Distribution of Zn2+-Transporters in Aged Rat Cardiomyocytes. |